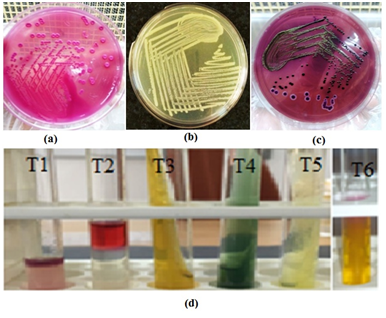
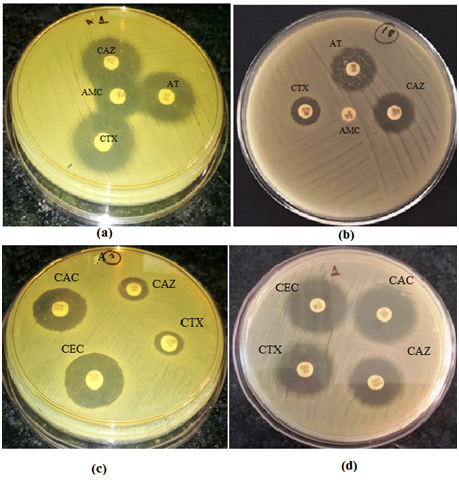
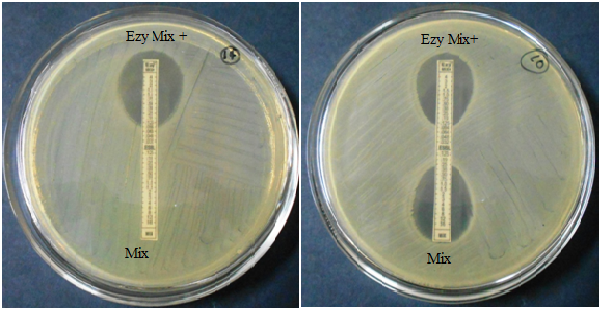

eISSN: 2576-4497


Review Article Volume 3 Issue 2
1Department of Bioscience and Biotechnology, Banasthali Vidyapith, India
2Department of Zoology, Rajasthan University, India
3Department of Life sciences, Amity University, India
Correspondence: Renu Bist, Department of Zoology, Rajasthan University, Jaipur, Rajasthan, India, Tel 91 74248 52622
Received: January 26, 2019 | Published: March 26, 2019
Citation: Mishra A, Bist R, Sharma V. Study of pervasiveness, antimicrobial vulnerability and resolution of best method for determining extended spectrum beta lactamases Escherichia coli isolates. Hos Pal Med Int Jnl. 2019;3(2):59-64. DOI: 10.15406/hpmij.2019.03.00152
Introduction: The growing frequency of infections due to extended spectrum β-lactamase (ESBL) enzymes is a global dilemma, and the existence of ESBLs fluctuates between countries.
Objective: To explored the occurrence of ESBLs producer E.coli in faecal carriage of humans, antimicrobial susceptibility profile and their viable threat factors.
Method: For study 40 faecal samples were evaluated for antibiotic susceptibility profile and ESBLs production of all enterobacterial E. coli was phenotypically tested by the CLSI recommended methods.
Result: ESBL E. coli was prevalent among all E. coli isolates and its frequency was recorded to be 72.9%. Current study revealed that ESBL producers E. coli or non ESBL producers E. coli both are highly susceptible to carbapenems and aminoglycosides class of antibiotics. Cefuroxime, cefaclor, and cefotaxime show high rate of resistivity followed by ampicillin, piperacillin, amoxicillin/clavulanic and amoxicillin/sulbactam in ESBLs as well as non ESBLs producers E. coli.
Conclusion: Higher antimicrobial resistivity was shown by ESBL producers E. coli than non ESBL producers E.coli.
Keywords: extended spectrum β-lactamases, E. coli, antimicrobial resistance, antibiotic
Gram negative bacteria (GNB) that have extended spectrum β-lactamase (ESBL) enzymes in clinical isolates have been documented as a most important public health challenge.1,2 β-lactamase enzyme are created by bacteria to hydrolyze the β-lactam ring in antibiotics, which confer resistance to bacteria and makes the drug treatment ineffective.3,4 ESBLs mediate bacterial resistance to β-lactam antibiotics having an oxyimino group (including third generation cephalosporins and aztreonam) and repressed by β-lactamase inhibitors, for example, clavulanic acid, tazobactam and sulbactam.5,6 ESBLs are expression products of plasmids and the genes which encoding these enzymes are moveable easily amongst different bacteria.7 Since 1983, after being first identified, they have been found globally. ESBLs exist in every region of the world and in most genera of enterobacteriaceae. These resistant isolates have been generally implicated in nosocomially obtained infections or outbreaks.8 Now ESBL producers are very frequent inside the community or in the wide healthcare settings.9 ESBLs are one of the major reasons of enhance in the incidence of colonization by multidrug resistance (MDR). The occurrence of MDR ESBLs in family Enterobacteriaceae is escalating swiftly and currently turns into a risk globally.10 Antibiotics uses generate a selective stress in the large intestine on host bacteria, mainly to the emergence of antimicrobial resistant organism, which in turn originate a raise in the quantity of carriers docking resistant bacteria and enhance the chance for bacterial infections.11 ESBL producing GNB are thought to be a crucial reason for the failure cephalosporin therapy.12,13 ESBL encoding genes that are mainly plasmid encoded comprise mostly TEM, SHV and CTX-M gene types.14,15 Enterobacteriaceae, such as Klebsiella pneumonia and Escherichia coli, are the primary ESBL producers. They confer bacterial resistance to penicillin and cephalosporin families that are common antimicrobial drugs.16 The colonization of ESBLs producer E. coli has been documented in both human being and animals and their prevalence increased drastically worldwide.17 Greater than 200 kinds of ESBLs were defined in various species of the family enterobacteriaceae and other non enteric organisms, with Pseudomonas aeruginosa and Acinetobacter genus. These organisms make variants of the TEM, SHV and CTX-M β-lactamases.18 Manifold variants of all gene are created with the aid of changing the configuration of amino acids within the β-lactamase active position.19,20
Carbapenems have been regard as the treatment alternative for severe infections as a result of ESBL producers. The mounting worldwide occurrence of ESBL linked infections is driving increased use of carbapenems drugs group, leading to choice stress for carbapenem resistance.8 ESBL resistance genes are specifically carried by plasmids. Plasmids may also convey genes encoding resistance to additional antibiotic class, including ampicillin A, ampicillin C, floroquinolone aminoglycosides, macrolides and chloramphenicol. Consequently, choice of treatment is confined for GNB that produce ESBLs due to the multiple resistance genes encoded within the plasmids.
Since, there is an increasing threat of MDR bacteria, it is cardinal to execute a program which detects and reports ESBLs as fraction of their infection manage to limit the failure therapy caused by ESBL producing bacteria.21 Therefore, current investigation deals with phenotypic and biochemical method to noticed and affirm antibacterial resistance due to ESBL producing bacteria.
Chemicals
MacConkey agar (MA), nutrient agar (NA), eiosin methylene blue (EMB) agar, Kovak’s reagent, methyl red, all antibiotics amikacin, ampicillin, ampicillin sulbactam, amoxiclave/clavunate, amoxicillin/sulbactam, aztreonam, cefaclor, cefotaxime cefuroxime, cefepime, ceftazidime, ciprofloxacin, co-trimaxazole, gentamicin, imipenem, levofloxacin, meropenem, netellin norfloxacin, ofloxacin, pipperacillin, pipperacillin/tazobactam, sparfloxacin, tetracycline, tobramicin and E-test strips under the study were purchased from Himedia (Mumbai, India).
Sample collection
Stool samples from patients who were on antibiotic dosages, were received in the Microbiology Laboratory of Escort Fortis Hospital, Rajasthan (India).
Processing of collected samples and selection of E. coli
Faecal samples were streaked on MA, NA and EMB agar. These petri plates were incubated aerobically for overnight at 37°C and they were observed for bacterial growth from obtained colonies and GNB were selected for study.
Morphological identification: GNB were identified on the basis of their morphological characteristics. Morphological study of bacterial colonies included colony shape, size, colour, elevation, margin, edges and Gram’s staining attributes.22
Biochemical screening: For the determination of colony characters various biochemical tests were performed such as catalase test, oxidase test, indole test, methyl red test, triple sugar iron test, Simmon’s Citrate Agar test, urease test and motility agar test. All biochemical tests were done in accordance to standard laboratory methods of identification for separation of E. coli isolates for the study.23
Antibiotic susceptibility testing
Antibiotic susceptibility testing was carried out using the Kirby Bauer disc diffusion method. Picked Three to five isolated E. coli colonies from the pure culture and suspended in 2-3ml of sterile peptone water in a test tube. The suspension turbidity was set to 0.5 Mc Farkland standards. The test organisms were inoculated on the surface of Muller Hinton agar (MHA) with sterile cotton swab by lawn culture method. The inoculated plate was left for 10 to 15 minutes and placed the discs on the surface of petriplate through a disc dispenser with gentle pressure. The discs were located evenly in such a way so that they were 15mm away from the rim of the Petridish and the gap between the centres of the two discs was around 24mm. Then plate were incubated at 37ºC for 16 to 18 hours.23
Screening of ESBL producing E. coli isolates
ESBL production was confirmed using the CLSI recommendations for ESBL screening and confirmation tests as described below.
Screening of ESBL E. coli isolates on Chromogenic agar: The screening of ESBL producer E. coli isolates was done by using HiCrome ESBL Agar Base according to manufacturer. HiCrome ESBL Agar Base is chromogenic screening medium for the selective isolation of ESBL producing organisms. Chromogenic mixture is used to differentiate the ESBL producing organisms on the basis of colour. Prepare the media by autoclaving at 15 lbs pressure (121°C) for 15 minutes. Then cool to 50°C and add two vials of HiCrome ESBL Selective Supplement (FD278). Mix well and transfer into sterilized Petri dish. Prepare the liquid suspension of 0.5 McFarland from stool samples or from pure isolated colony. Then streak on the surface of petriplate and incubate aerobically at 37°C for overnight. ESBL producer E. coli produces pink or purple colour colonies.24
Double disc synergy test (DDST): Prepare a lawn culture by isolated bacteria on the surface of MHA. DDST was performed by placing a disk of amoxiclav/clavulanic acid (20/10µg), third generation cephalosporin (30µg) and aztreonam (30µg) were placed accordance to CLSI guidelines for anti microbial susceptibility test.25
Phenotypic confirmatory disc diffusion test (PCDDT): The probable ESBLs E. coli isolates were confirmed for the production of ESBL by phenotypic confirmatory disc diffusion test (PCDDT) as CLSI guidelines recommended for antimicrobial vulnerability tests. The antibiotics ceftazidime (30µg) and cefotaxime (30µg), alone and in combination with clavulanic acid (10µg) (beta-lactamase inhibitor) were used.26
E-test: In current study two types of E-test strips were used for the detection of ESBLs E. coli.27 E-test strips are porous paper drug saturated strips. These E-test strips are generated a constant concentration gradient of ceftazidime/ cefotaxime-clavulanate (mix/mix+) (MIC test range, 0.125-4mcg/ml) on one end and the remaining end generates a gradient of ceftazidime/ cefotaxime (MIC range, .125 to 16mcg/ml) plus 4 mcg/ml clavulanic acid. Similarly recently introduced cefepime/cefepime-clavulanate (cpm/cpm+) Etest ESBL strip have cefepime (MIC test range, 0.25-16 mcg/ml) and cefepime (MIC range, 0.064-4 mcg/ml) plus 4mcg/ml clavulanic acid. E-test strip technique, psychiatry, and their reading were carrying out accordance to the manufacturer’s directives.
The significant of finding ESBLs producer E. coli was compared with non ESBLs producers by the means of Chi square test (SPSS 20). P value was evaluated and regarded as significant when it was >0.05.
Current investigation involved screening of a total of 40 samples for revealing ESBL E. coli.
E. coli ATCC 25922 and K. pneumoniae ATCC 700603 strains were used as negative and positive control.
Morphological screening (Table 1 & Figure 1A–1C)
Out of 40 stool samples studied, a total of 37 isolates of E. coli were identified on the basis of their morphological traits. They were pink in colour, rod shaped (individually) yet in circular colonies, Colony is pink on MA due to lactose fermentation, whereas in NA white colonies are obtained. EMB agar produced a distinctive metallic green sheen on E.coli colonies. They are circular, Small (2-3mm in diameter), convex, smooth, with entire margin and translucent and non mucoid.
S. No |
Characteristics |
Observation |
1 |
Shape |
Circular |
2 |
Size |
Small; 2-3mm diameter |
3 |
Colour |
Pink (lactose fermenting) in MA, white in NA and metallic green in EMB agar |
4 |
Elevation |
Convex |
5 |
Margin |
Entire |
6 |
Edges |
Smooth |
7 |
Light transmittance |
Translucent |
8 |
Gram’s stain |
Gm-ve |
Table 1 Colony morphology and staining attributes of E. coli revealed in stool samples
EMB, eiosin methylene blue agar; MA, MacConkey agar; NA, nutrient agar
Biochemical tests (Figure 1D)
In biochemical screening E. coli isolates showed positive reaction for catalase, indole, and methyl red, whereas negative response recorded in the case of oxidase. E. coli isolates with triple sugar iron test showed gas production (A/A). They showed negative reaction for Simmons citrate agar and urease enzyme and motile in mannitol motility agar.
Figure 1 Morphological attributes and of E. coli colonies grown over (A) MacConkey agar, (B) nutrient agar (C) eosin methylene blue agar and (D) biochemical reactions of E. coli isolates. A/A, Acidic/acidic; T1, indole test; T2, methyle red test; T3, triple suger iron test; T4, simmon citrate agar test; T5, urease test; T6, mannitol motility agar test
Antibiotic sensitivity testing (Figure 2)
Current study revealed that ESBL producers E. coli or non ESBL producers E. coli both are highly susceptible to imipenem 83.7%, meropenem 94.5% and aminoglycosides 94.5% group of antibiotics. Cefuroxime, cefaclor, and cefotaxime show high rate of resistivity followed by ampicillin, piperacillin, amoxicillin/clavulanic and amoxicillin/sulbactam in ESBLs as well as non ESBLs producers E. coli. Whereas resistivity pattern towards ceftazidime and cefipime was 48.6% and 51.3%. Floroquinolones, trimethoprim/sulfamethoxazole, tetracycline are moderate sensitive for all E. coli isolates between 32 to 54%. Susceptibility to other β-lactam inhibitors is good between 70 to 78%. E. coli isolates from stool sample showed susceptibility to third generation cephalosporin was further decreased. ESBLs producers showed homogeneity in the resistance pattern, which were multi drugs resistant with at least a resistance to 16 antibiotics out of the 25 tested. E. coli showing higher resistance to cefotaxime 92.5% in ESBL producers and 30% in non ESBL producers compared to ceftazidime 51.8% in ESBL producers and 10% in non ESBL producers. Higher resistance was shown by ESBL producers than non ESBL producers.

Figure 2 Diagram exhibiting a comparison of antibiotic resistance between ESBL producers and non ESBL producers. AMP, ampicillin; AT, azeotranum; PI, pipperacillin; CXM, cefuroxime; CF, cefaclor; CTX, cefotaxime; CAZ, ceftazidime; CPM, cefepime; AMC, amoxicillin/clavunate; AMS, amoxicillin/sulbactam; A/S, ampicillin/sulbactam; PIT, piperacillin/tazobactam; TOB, tobramicin; GEN, gentamicin; AK, amikacin; NET, netilmicin; CIP, ciprofloxacin; LE, levofloxacin; SPX, sparfloxacin; NX, norfloxacin; OF, ofloxacin; COT, co-trimoxazole; TE, tetracycline; IMP, imipenem; MRP, meropenem
Confirmation of ESBL producers
Confirmation using chromogenic agar (Figure 3): Pink to burgundy, translucentcolonies were produced on ESBL screen chromogenic agar. We revealed 67.5% E. coli isolates as ESBLs producers by using Hichrome ESBL agar base.
DDST (Figure 4A & 4B): In DDST, Out Of the 37 E. coli isolates screened for ESBL production, by DDST, ESBLs positive occurrence rate was revealed to be 48.6%.
PCDDT (Figure 4C & 4D): The overall prevalence of ESBLS producer E. coli was revealed to be 72.9% by PCDDT. Out of 27 ESBLs producer isolates 17 showed positive results with ceftazidime and cefotaxime and 8 showed positive tests with only cefotaxime and remaining 2 with ceftazidime.
Figure 4(a ,b, c and d) E. coli isolates showing Double disc synergy test and phenotypic confirmatory disc diffusion test (A) DDST positive E. coli isolate; (B) DDST negative E. coli isolate; (C) PCDDT positive E. coli isolate; (D) PCDDT negative E. coli isolate.
AMC, amoxicillin/clavunate; AT, azeotranum; CAC, ceftazidime/ clavulanic acid; CAZ, ceftazidime; CEC, cefotaxime/ clavulanic acid; CTX, cefotaximeE-Test (Figure 5A–5D): ESBL positive E. coli isolates were further confirmed by E test ESBL strips. Regarding the results of E-strip test, The MIC was interpreted as the point of intersection of the inhibition ellipse with the edge of the test. E-test strips for (MIX+/MIX) and (CPM+/CPM) gave MIC value greater than 8 or not produce zone for MIX and CPM which indicated the presence of 27 ESBL E. coli.
Figure 5 (A-D)
E. coli isolates showing E-tests for ESBL confirmation
A significant association in prevalence of ESBL producer and ESBL non producer E. coli isolates was revealed (P<0.01) (Figure 6).
ESBL producing family enterobacteriaceae are raising concern globally and currently a most important confronts to clinicians, communal health experts, and hospice infection control panel.
In the present study, we investigated ESBL producer E. coli isolates and susceptibility pattern towards a variety of antimicrobial drugs. Organisms producing ESBLs are clinically proven applicable cause of failure of cephalosporins therapy.28 ESBLs are mostly produced by with the aid of the family enterobacteriaceae, in K. pneumoniae and E. coli. Bacteria harbouring ESBLs also acquire and most often exhibit supplementary resistances to other antimicrobial classes such as the floroquinolones, tetracyclines, co-trimoxazole, and aminoglycosides, its further restrict the therapeutic alternative and thus cause a therapeutic quandary.29
Current study revealed 37 E. coli isolates out of the 40 stool samples because E. coli bacterium is frequently found in gut of human and animals. Most of the strains of E. coli are part of beneficial bacterial flora in human gut, however a few are reported to cause infections in humans. ESBLs producing E. coli express resistivity to antibiotics used in treating infections.
Current investigation used different screening and confirmatory tests for the detection of ESBLs producing E. coli isolates and recorded 72.9% E. coli isolates with ESBLs production. Present study confirmed that PCDDT and E-test of ESBLs detection are most sensitive than DDST method.27,30 The high percentage of ESBLs producer E. coli was found. It may be due to overuse of antibiotics, prolonged hospital stay and long time exposure of antibiotics.31 A widespread resistance to third-generation cephalosporins among Enterobacterial E. coli was recorded.32 ESBLs producer E. coli isolates were found resistant to amplicillin, piperacillin as well as extended-spectrum cephalosporin which is also in agreement according to the findings.33 ESBLs producers also showed resistivity to some other class of antibiotics, such as floroquinolones and co-tromoxazole.34,35 Current study reported that Cabapenemase group of antibiotics are found highly susceptible to ESBLs producer as well as non ESBLs producer may be due to the stability and the high activity of carbapenem against most β-lactamases. Therefore, extended spectrum carbapenems are recommended to treat infections caused by ESBL producing bacteria.36 Present investigation reported the susceptibility rates to β-lactam inhibitor such as ampicillin/sulbactam and piperacillin/tazobactam in the ESBL E. coli 70.3% and 66.6%, respectively, were higher than those to cefotaxime, ceftazidime, and cefepime because β- lactam inhibitors be able to inhibit ESBL enzyme activity, and hydrolysis of bond. And also they were not highly use for treatment of community acquired infections. So they are considered an alternative group of drugs beside carbapenems to treat infections due to ESBL producing bacteria.37 Whereas, amoxicillin/clavunate 86.4% and amoxicillin/sulbactam 94.5% showed highly resistant to ESBLs as well as non ESBLs producer E. coli isolates because of their extreme uses.
High degree of susceptibility rate was observer to aminoglycosides drugs 94.5% for both ESBLs and non ESBLs producer E. coli isolates. Hence, in the group ESBL producers aminoglycosides may have contributed to the non-noteworthy findings in the medical and microbiological responses among the ESBL producers and non-ESBL producers. Aminoglycosides contain excellent action adjacent to clinically important GNB. Aminoglycosides are main class of antibiotics which shows activity against many gram-negative rod shape bacilli. The enzymatic modification of antibiotic molecule is the common mechanism of aminoglycosides resistance. Aminoglycosides class show lesser resistance rates because they are injectable vaccines so restrictively used by community and health care settings.38
Findings of current research present the high prevalence of MDR ESBLs E. coli which imposes significant threat to public health. Surveillance antibiotic resistivity’s of ESBL positive E. coli isolates ensure the careful use of antimicrobial drugs. Present study also concluded that PCDDT and E-test were best optimized methods for detection of ESBL producing organisms.
We would like to thank Prof. Aditya Shastri for help with managing our lab facilities on Banasthali University and running this study. We would also like to thank the Banasthali University, Rajasthan, India and Escort Fortis Hospital Rajasthan, India for providing lab facilities and samples, respectively.
The authors declare there is no conflict of interest.

©2019 Mishra, et al. This is an open access article distributed under the terms of the, which permits unrestricted use, distribution, and build upon your work non-commercially.